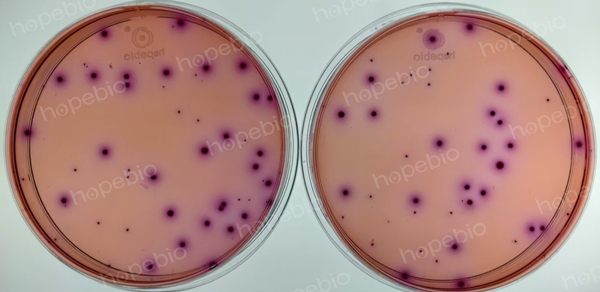

海博微信公众号
海博微信公众号
 海博天猫旗舰店
海博天猫旗舰店


 海博微信公众号
海博微信公众号
 海博天猫旗舰店
海博天猫旗舰店




一、标准简介
在《GB4789.3-2025 食品安全国家标准 食品微生物学检验 大肠菌群检验》标准中,介绍了MPN法和平板计数法检验食品中大肠菌群的方法。相比较于上一版本的平板计数法,新版对平板计数法的计数规则做了更详细的拆分和说明。
二、平板计数法
新标准中对典型菌落和可疑菌落做了分类计数(因为实际检验中,典型菌落和可疑菌落阳性的概率不相等,典型菌落阳性概率远大于可疑菌落的阳性概率,所以有必要将典型菌落与可疑菌落进行分开计数),如下图中,紫红色较大,周围伴有沉淀环的为典型菌落,而较小的菌落则为可疑菌落,将平板上的两种菌分别独立计数,并各挑取5个进行BGLB确认试验。
图1 VRBA 10-1稀释度

图2 VRBA 10-2稀释度
对以上两个稀释度的平板典型和可疑菌落分别计数如下表:
|
稀释倍数 |
10倍稀释 |
100倍稀释 |
||
|
平板编号 |
1 |
2 |
1 |
2 |
|
菌落总数 |
54 |
44 |
5 |
5 |
|
典型菌落 |
30 |
24 |
2 |
3 |
|
可疑菌落 |
24 |
20 |
3 |
2 |
|
典型菌落总数 |
30+24=54 |
2+3=5 |
||
|
可疑菌落总数 |
24+20=44 |
3+2=5 |
||
由于100倍稀释度的菌数不在要求的15-150CFU内,因此只计算10倍稀释度的平板,从54个典型菌落中挑取5个菌落接种BGLB,从44个可疑菌落中挑取5个菌落接种BGLB,培养结束后,典型菌落有4个产气,可疑菌落都不产气,则结果计算为:
(54×4/5+44×0/5)÷2×10(稀释倍数)=220
结果报告为220CFU/g。
注:本文属海博生物原创,未经允许不得转载。
下一篇:没有了!
| 相关文章: | ||



